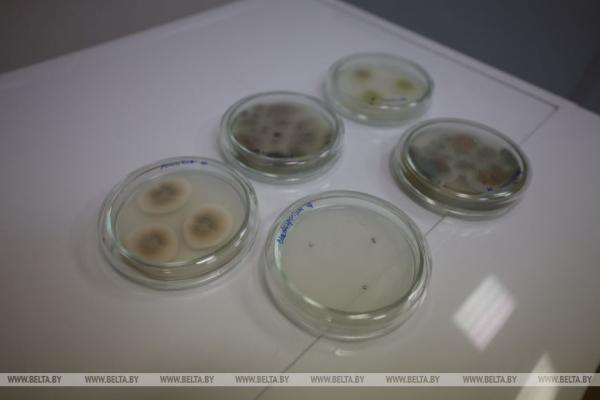
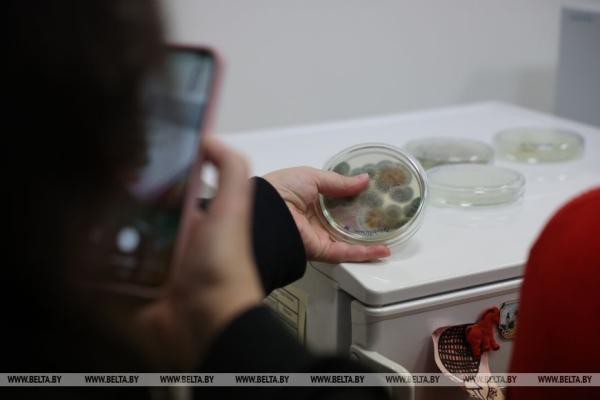

Республиканская акция «Библионочь-2026», приуроченная ко Всемирному дню книги и авторского права, традиционно встретила любителей чтения в Национальной библиотеке Беларуси. Здесь их ждали десятки тематических площадок: лекции, мастер-классы, экскурсии, творческие встречи, игры для детей и взрослых и другие познавательные развлечения. Корреспонденты БЕЛТА посетили главную библиотеку страны и узнали, чем она порадовала и удивила новых гостей и постоянных посетителей.





Генеральный директор Национальной библиотеки Вадим Гигин отметил, что этом году в «Библионочи» принимает участие рекордное количество библиотек — 149. В НББ главными темами акции стали Год белорусской женщины и 20-летие нового здания библиотеки, которое отметят в июне.

«Это уникальное, прекрасное здание — один из символов нашего суверенитета, и мы посвятили этому наши многочисленные площадки. Миссия библиотек — просвещение — не меняется, но, конечно же, изменяются формы и методы наших действий. Мы хотим показать возможности и потенциал, который есть в нашем здании, начиная даже не с первого этажа, а с подвальных помещений, где еще никто никогда не бывал, до обзорной площадки, где гостей ждет сюрприз», — сказал Вадим Гигин.



По его словам, библиотека подготовила около трех десятков площадок и экскурсии, которых не было раньше. Например, ночные экскурсии по библиотеке, которые покажут, чем живут книги, когда уходят читатели. Интересны новые мастер-классы, посвященные реставрации, и просветительский диджей-сет, а также выставочный проект «Женское пространство».
«В любом случае, каких бы развлечений здесь ни было, наша основная задача показать, что книга — это интересно и увлекательно, это особый атмосферный мир, в который можно погружаться. С книгой можно дружить, с ее помощью можно заводить новые знакомства и, самое главное, прокладывать путь в будущее. Это основная мысль, которую мы хотим донести с помощью многочисленных площадок, работающих здесь сегодня», — пояснил гендиректор.




По его мнению, белорусы любят разные книги. Так, в период сессии студентам более интересна учебная литература, а в другое время растет популярность развлекательных жанров.



«В этом нет ничего плохого, такая литература помогает занять время. Многие новые сведения получают из развлекательной литературы, тот же Жюль Верн или наши классики. «Полесские робинзоны» и «Амок» Янки Мавра считались развлекательной литературой, зато какой! Важно качество. Когда чтение становится функциональным, читатель умеет ориентироваться в этом огромном мире книг. Библиотекари — лоцманы, которые должны проложить им дорогу», — поделился своим мнением Вадим Гигин.

Декан факультета социокультурных коммуникаций БГУ Александр Бурачонок подчеркнул, что университет очень давно сотрудничает с Национальной библиотекой. «Не секрет, что она когда-то появилась в стенах Белорусского государственного университета и потом уже развилась в самостоятельное учреждение. Безусловно, формат этого мероприятия полностью соответствует открытости БГУ, и мы очень рады показать свои достижения в области образования и науки. Мы подготовили для посетителей несколько разнообразных мастер-классов по химии, экономической науки и биологии», — заметил он.
Александр Бурачонок уверен, что студенты БГУ остаются верны традициям и продолжают ходить в библиотеку, ведь несмотря на цифровизацию ничто не заменит общение с книгой. Здесь студенты получают знания в полном объеме и могут сформировать представление о своей отрасли.
Сегодня участники «Библионочи» смогли узнать много нового о белорусских традициях, посетив лекции, связанные с историей белорусской свадьбы, и приняв участие в познавательных настольных играх. Также они ближе познакомились с Китаем, побывав на лекции «Фэншуй или китайская метафизика», мастер-классах по китайским шахматам и традиционной живописи на площадке Китайского культурного центра и Института Конфуция БНТУ.
Как рассказал директор Института Конфуция по науке и технике БНТУ Ли Вэньсюэ, они принимают участие в «Библионочи» уже третий раз. В этом году провели мастер-класс по каллиграфии и представили выставку китайской живописи.
Среди библиотечных площадок было много предназначенных для маленьких посетителей: познавательный квест, игротека, музыкальные выступления. Студенты Минского государственного художественного колледжа имени А. К. Глебова представили на акции свой VR-проект. «Я обучаю людей рисовать в VR-очках, провожу небольшой мастер-класс и даю им попробовать себя в этой сфере. В первую очередь молодых людей и детей, которые интересуются современными технологиями, но это новшество интересно и людям постарше. Принцип работы практически такой же, как и в любом компьютерном графическом редакторе. Джойстик служит мышкой, которая рисует в пространстве. Можно представить, что в руках у вас кисть и рисовать в определенной плоскости», — пояснила студентка колледжа Анна.






Она подчеркнула, что колледж уже представил уникальный VR-проект в Национальном художественном музее рядом с картиной Марка Шагала, а также создавал локации, посвященные любимым советским мультфильмам для фестиваля «Анимаевка».



«Библиночь» оставила приятные впечатления у участников акции. Каролина Матвеева пришла в библиотеку вместе с родителями в первый раз и уже хочет сюда вернуться. «Мне все очень понравилось, особенно рисовать и играть в настольные игры. Я вижу, что здесь очень много книг, и мне бы было интересно прийти сюда еще раз, чтобы познакомиться с новыми сказками», — заметила она.





Юлия посещает акцию во второй раз. «Я изучаю китайский, поэтому мне интересны мастер классы по китайскому языку, живописи и культуре. Вижу, что с каждым годом все больше людей привлекает «Библионочь». Конечно, было бы здорово посетить другие библиотеки, потому что я видела в программе интересные события, но, к сожалению, за один вечер все не успеть», — призналась она.

«В этом году я собираюсь поступать в магистратуру, поэтому часто захожу сюда и интересуюсь литературой, которая поможет мне в подготовке. Здесь хранится огромный фонд книг, авторских работ и диссертаций, на которых можно основывать свои исследования, поэтому я рада, что библиотека продолжает развиваться и привлекать новых читателей», — подытожила Юлия.
БЕЛТА.

 НОВОСТИ В БЕЛАРУСИ
НОВОСТИ В БЕЛАРУСИ



